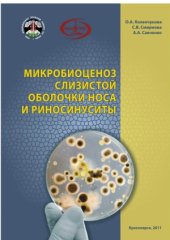
book Микробиоценоз слизистой оболочки носа и риносинуситы

- Author: Савченко Алла Леонидовна
- Language: Русский

За перевалом
djvu
- Author: Савченко В.
- Language: Русский
- Year: 1984

За перевалом
pdf
- Author: Савченко В.
- Language: Русский
- Year: 1984

- Author: М. Савченко (ред.)
- Language: Русский
- Year: 2017
- Author: Коленчукова О.А. Смирнова С.В. Савченко А.А.
- Language: Русский
- Year: 2011

- Author: Савченко И. А.
- Language: Русский

- Author: Савченко И. А.
- Language: Русский


